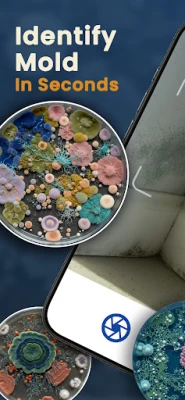

Jaunākā versija
Atjauninājums
martā 01, 2026
martā 01, 2026
Izstrādātājs
EmberNext LLC
EmberNext LLC
Kategorijas
Izglītība
Izglītība
Platformas
Android
Android
Instalācijas
1
1
Licence
Free
Free
Pakotnes nosaukums
com.embernextllc.moldidentifier
com.embernextllc.moldidentifier
Ziņot
Ziņot par problēmu
Ziņot par problēmu
Vairāk par Mold Identifier: Al Scan & ID
"Mold Identifier: Al Scan & ID" izmanto AI, lai tūlītēji identificētu pelējumu. Analizējiet fotoattēlus, uzziniet veidu un riska līmeni, kā arī saņemiet padomus tā novēršanai, lai pasargātu savu mājokli.
Vai Jūs uztraucaties par nepatīkamiem plankumiem uz sienām vai griestiem? Atvadieties no minējumiem un iegūstiet skaidrību ar **Mold Identifier: AI Scanner**. Šī inovatīvā lietotne izmanto modernu mākslīgo intelektu, lai nekavējoties analizētu potenciālā pelējuma fotoattēlus, sniedzot Jums precīzas atbildes un rīcības plānu tā novēršanai. Neatkarīgi no tā, vai esat mājas īpašnieks, kurš cīnās ar mitru pagrabu, īrnieks, kuru satrauc gaisa kvalitāte, vai īpašuma pārvaldnieks, kurš veic vienību inspekcijas, **Mold Identifier: AI Scanner** ir Jūsu uzticamais kabatas eksperts veselīgākai videi.
Lietotnes galvenais spēks ir tās tūlītējā AI detekcija. Vienkārši uzņemiet vai augšupielādējiet attēlu, un mūsu AI salīdzinās to ar plašu sēnīšu datu bāzi, identificējot specifiskus pelējuma veidus, piemēram, Stachybotrys (melno pelējumu), Cladosporium vai Chlorophyta. Pēc identifikācijas **Mold Identifier: AI Scanner** nekavējoties sniegs riska novērtējumu (zems, vidējs, augsts), palīdzot Jums saprast situācijas steidzamību. Vairs nav jāmeklē sarežģīti tīrīšanas padomi internetā – lietotne piedāvā konkrētas "Ieteiktās darbības", tostarp drošus DIY risinājumus un svarīgus brīdinājumus.
Turklāt, lai nodrošinātu ilgtermiņa risinājumus, **Mold Identifier: AI Scanner** sniedz vērtīgus profilakses pasākumus. Uzziniet, kā kontrolēt mitrumu, uzlabot ventilāciju un pārvaldīt mitrumu, lai novērstu pelējuma atkārtotu parādīšanos. Visi jūsu skenējumi tiek saglabāti vēstures žurnālā, kas ļauj viegli sekot līdzi situācijas attīstībai vai pierādīt problēmu īpašniekiem un darbuzņēmējiem. Izvēloties **Mold Identifier: AI Scanner**, Jūs iegūstat ātru, precīzu un viegli lietojamu rīku ar detalizētām atziņām un tīru, intuitīvu saskarni. Pārņemiet kontroli pār savu iekštelpu gaisa kvalitāti jau šodien!
Lietotnes galvenais spēks ir tās tūlītējā AI detekcija. Vienkārši uzņemiet vai augšupielādējiet attēlu, un mūsu AI salīdzinās to ar plašu sēnīšu datu bāzi, identificējot specifiskus pelējuma veidus, piemēram, Stachybotrys (melno pelējumu), Cladosporium vai Chlorophyta. Pēc identifikācijas **Mold Identifier: AI Scanner** nekavējoties sniegs riska novērtējumu (zems, vidējs, augsts), palīdzot Jums saprast situācijas steidzamību. Vairs nav jāmeklē sarežģīti tīrīšanas padomi internetā – lietotne piedāvā konkrētas "Ieteiktās darbības", tostarp drošus DIY risinājumus un svarīgus brīdinājumus.
Turklāt, lai nodrošinātu ilgtermiņa risinājumus, **Mold Identifier: AI Scanner** sniedz vērtīgus profilakses pasākumus. Uzziniet, kā kontrolēt mitrumu, uzlabot ventilāciju un pārvaldīt mitrumu, lai novērstu pelējuma atkārtotu parādīšanos. Visi jūsu skenējumi tiek saglabāti vēstures žurnālā, kas ļauj viegli sekot līdzi situācijas attīstībai vai pierādīt problēmu īpašniekiem un darbuzņēmējiem. Izvēloties **Mold Identifier: AI Scanner**, Jūs iegūstat ātru, precīzu un viegli lietojamu rīku ar detalizētām atziņām un tīru, intuitīvu saskarni. Pārņemiet kontroli pār savu iekštelpu gaisa kvalitāti jau šodien!
Novērtēt lietotni
Pievienot komentāru un atsauksmi
Lietotāju atsauksmes
Balstīts uz 0 atsauksmēm
Vēl nav pievienota neviena atsauksme.
Komentāri netiks apstiprināti publicēšanai, ja tie ir surogātpasts, aizskaroši, neatbilst tēmai, satur lamuvārdus, personiskus uzbrukumus vai veicina jebkāda veida naidu.
Vairāk »










Populāras lietotnes

Bookshelf-Your virtual librarySquidBit

Elpošanas vingrinājumiATA App

Listă de Cumpărături și OferteDaniLex Soft

Find Level: Bubble, Laser ToolVasundhara Infotech LLC

Idle : Mold FarmPond studio

TAMM - Abu Dhabi GovernmentDepartment of Government Enablement

Bubble level for androidIDAFN Technology

Antique Identifier - AntiquebyPixoby OU

AIMPArtem Izmaylov

Zvejas MezgliFISH PLANET APPS